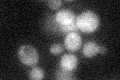
YDR303C
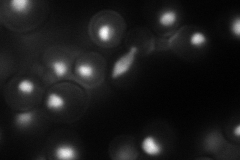
YDR303C
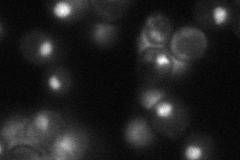
YDR303C
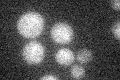
YDR303C

View description
Component of the RSC chromatin remodeling complex; essential gene required for maintenance of proper ploidy and regulation of ribosomal protein genes and the cell wall/stress response; highly similar to Rsc30p
Localization:
Intensity:
Fold change:
Significance:
-
C’ GFP library in SD
nucleus20.35 -
N' NOP1pr-GFP in SD
nucleus74.6029 -
N' TEF2pr-mCherry in SD

nucleus,nucleolus168.18 -
N' NATIVEpr-GFP in SD
nucleus51.526 -
N' TEF2pr-VC and Cyto-VN in SD

nucleus33.2382 -
C’ GFP library in SD+DTT

nucleus16.540.81No -
C’ GFP library in SD+H2O2

nucleus17.510.86No -
C’ GFP library in Starvation Media
nucleus15.340.75No -
C’ GFP library on the background of Pup2-DaMP

nucleus -
C’ GFP library on the background of CCT mutant

nucleus21.70581.06637No
